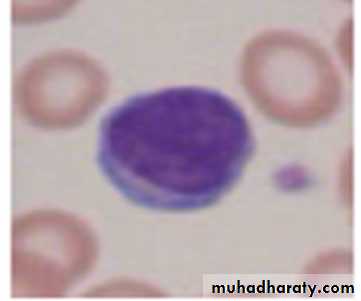

IRON deficiency anemia
د .خالد نافعباطنيه
Iron in the body is used primarily for the synthesis of Hemoglobin and normal erythropoiesis requires 20-25 mg of iron per day.
Requirements for exogenous iron
All iron required for red cell production is acquired through the recycling of iron extracts from the senescent red cells.
Only 5% of the iron needed for erythropoiesis, or 1 mg /d, is absorbed from GIT to balance losses in the urine, stool, sweat , and de-sequamated skin
IRON STORAGE
Two different configurations :Ferritin : water soluble, hydroxyl iron, & protein (Apoprotein
Hemosiderin : insoluble Aggregate of ferritin molecules that have been stripped of apoprotein.
Metabolic pathway of IRON
Phagocytic macrophages in the liver, spleen, BM take RBC that have complete their 120-day life span. Hemoglobin is broken down into its constituents and iron is stored as ferritin or hemosiderin.Erythroid precursors in the marrow develop around the macrophages and take up the ferritin.
Macrophages in the marrow and spleen remove excess ferritin and hemosiderin.
Transferrin mediate iron transport from macrophages and gastro-intestinal mucosa to the immature RBC and for storage in the liver
. Iron transport
Transferrin is the principle means for moving iron and is a transport protein with two iron binding site. transferrin picks up iron from the mucosal cells of the intestine then deliver iron to receptors on surface of nucleated RBCs and reticulocytes .the macrophages then transport the iron-free transferrin back to the place .
The amount of transferrin in the serum is measured directly as the total iron binding capacity(TIBC).
Iron Absorption
Absorption sites : maximal absorption occur in the duodenum and upper jejunum.
The acidic gastric juice reduces insoluble ferric iron to its soluble ferrous state.
Factors influence iron absorptionIncrease Fe absorption Decrease Fe absorption
- Acids : HCl ,vit.C -Alkalis, antacids
- ferrous iron (Fe+2) pancreatic secretion
- Agents that solubilize iron organic iron, Ferric iron
as(sugars, amino acids) Agents precipitate Iron as
- Iron deficiency Phytate in the tea and Increased demand as in phosphate in the bran)
pregnancy, infancy , excess iron utilization
adolescence,Hemolysis infection or inflam
or bleeding disorder
-primary hemochromatosis
iRON DEFICIENCY ANAEMIA (Ida)
Stages of iron deficiency
a. Depletion of tissue iron.
Reduced levels
of serum ferritin
Reduced levels
of serum ferritin
in negative iron balance, and to preserve the level of iron in the serum and RBC, results in Depleting the tissue iron stores and this results in
:
IDA
b. Changes in serum iron are indicative of depletion of the iron stores :
Serum iron are usually low.
TIBC increase.
c. Progressive anaemia :
initially normochronic, normocytic
eventually hypochromic, microcytic
tissue changes occur.
CAUSES OF IRON DEFICIENCY
Chronic blood loss:uterine blood loss.
GIT blood loss.
Benign conditions:
peptic ulcer.
esophageal varicies.
hiatus hernia.
colonic diverticula or polyp.
hemorrhoids.
chronic aspirin use.
Parasites (hook worm).
*Malignancy:
colonic ;colorectal Ca.
Gastric Ca.
Esophageal Ca.
small intestinal Ca
Causes of IDA cont
. pulmonary accumulation lead to hemosiderosis.
Hypernephroma.
urinary tract Bladder Ca.
paroxysmal nocturnal
hemoglobinuria (PNH).
Increase iron requirement
Iron malabsorption
Poor diet
SYMPTOMS OF IRON DEFICIENCY
symptoms and signs pertaining to anaemia
. Non-specific symptoms :fatigue, weakness , dyspnoea, symptoms of CHF
. Signs : Pallor, tachycardia, splenomegaly (minority of cases
. Symptoms and signs specific to iron deficiency :
. atrophic changes in the epithelium results from levels of heme-containing enzymes (cytochrome, succinate dehydrogenase, catalase, peroxidase, xanthine oxidase) :
a. oral lesions :
angular cheilosis
Atrophy of the tongue papilla with intermittent glossitis, and stomatitis.
Dysphagia : post-cricoid esophageal webbing (Plummer Vinson syndrome).
Nail lesions : (Koilonychias) Flattening , thinning lead to brittle, spoon- shaped nail.
Pica : Compulsive ingestion of non nutritive substances.
Children craving for & ingestion of clay, dirt, paint
Adult : to eat ice (pagophagia) clay.
DIAGNOSIS
Laboratory studies :a. peripheral blood :
RBC indices :
MCV (55-74 fl)
MCH (25-30 g/dL)
RDW > 16
. Peripheral blood smears :
microcytic hypochromic
poikilocyte = abnormally shaped RBCs.
Anisocyte = vary in size of RBCs.
. Blood count :
normal or low reticulocytes
occasionally high platelet count
Differntial diagnosis of microcytic anaemiaSideroblastic anaemia
Thalassaemia trait
Anaemia of chronic disorderes
IRON
Deficiency
anaemia
Transpart iron
N or high
N or high
N
N
Low
NR or low
Low
low
*plasma iron
*saturation of TIBC
Storage iron
N or high
N
N or high
low
Plasma ferritin
N or low
N
N or low
high
Plasma TIBC
N or high
N
N or high
low
Marrow iron
Investigation-cont
b. serum iron studies :
the level of serum iron is low or normal depending on what patient eat before the measurement.
TIBC > 400 µg/dL
Transferrin saturation <15 %
Serum Ferritin < 12 ng/ml.
Soluble transferrin receptor ; increased
C. Bone marrow studies :
Absence of iron in macrophage when the sample is subjected to Perl's stain (Prussian blue stain
TREATMENT
1- Determine the cause of iron deficiency.
stool for occult blood loss from GIT bleeding.
radiological analysis of upper & lower GIT for occult malignancy.
urine analysis for hematuria.
CXR for pulmonary Hemosiderosis.
Pelvic exam. In woman .
Serum antiendomysial antibody or anti- transglutaminase antibodies and
possibly a duodenal biopsy are indicated to
detect coeliac disease
.
-2.Treat the underlying cause. 3.Initiate iron replacement therapy :
oral iron therapy :
Ferrous sulfate.
Ferrous fumarate and gluconate.
Dosage :
The adult dose of ferrous sulfate is 300 mg/day gradually increased to 900 mg /day if tolerated.
Adverse effect :
GIT irritation : nausea, cramping, diarrhea
.
INDICATION OF parentral iron therapy
can not tolerate the side effect of oral iron.
Suffers from inflammatory bowel disease and peptic ulcers.
Does not comply with prescribed dosage.
Iron mal-absoption.
Suffers from condition such as hereditary hemorrhagic telengectasis (HHT) in which the rapid loss from continuous bleeding can not be compensated by oral iron.4. Transfusion of whole blood or packed red cells is generally not indicated unless a rapid increase in haematocit is critical to the patient
PREPARATIONS
1.Iron dextran (imferon) Intramuscular injection. it may lead to hypersensitivity reaction and anaphylaxis to the dextran and permanent stain with discoloration at the injection site. The later can be avoided by using the Z technique of IM injection.
2.Iron sorbitol (Jectofer) IV .A small test dose 0.25 ml of the drug should be administered before IM or IV to determine hypersensitivity to the agent
Dose in ml = 0.0476 x weight (kg) x (Hb. deficit) + 1 ml/5kg to a maximum of 14 ml to replete iron stores.The total dose can be diluted in normal saline at 1:20 dilution and infused slowly over several hours.
3.Iron sucrose IV in patient who are allergic to dextran.
. 4.new preparations of iron isomaltose and ironcarboxymaltose have fewer allergic effects and are preferred
Maintain iron replacement therapy :
the treatment should be extended to beyond the point where the anaemia is corrected for a pertiod of usually 3-6 months in order to replenish depleted iron stores.
- A failure to respond to iron therapy should suggest the following :
incorrect diagnosis
continued loss of iron.
Presence of chronic infection or inflammation will suppress BM activity .
Lack of pt. Compliance.
Inffective release of iron.
Malabsorption of iron.
Ida criteria
LOW HB
LOW HCT
LOW MCV
LOW MCH
MCHC LOW / N
LOW FERRITIN
LOW FE
HIGH TIBC
HIGH RDW
Anaemia of chronic disease
Anaemia of chronic disease (ACD) is a common type of
anaemia, particularly in hospital populations.
It occurs
in the setting of chronic infection, chronic inflammation
or neoplasia.
The anaemia is not related to bleeding,
haemolysis or marrow infiltration
is mild, with haemoglobinin the range of 85–115 g/L, and is usually associatedwith a normal MCV (normocytic, normochromic),though this may be reduced in long-standing inflammation.The serum iron is low but iron stores are normal orincreased, as indicated by the ferritin or stainablemarrow iron
Pathogenesis
ACD is The regulatory protein that accounts for the findings characteristic of
which is produced by the liver Hepcidin
production of hepcidin is induced by proinflammatory cytokines, especially
IL-6.
Hepcidin binds to ferroportin on the membrane of iron-exporting cells,
such as small intestinal enterocytes and macrophages,
internalising the ferroportin and thereby inhibiting the
export of iron from these cells into the blood.
The iron
remains trapped inside the cells in the form of ferritin,
levels of which are therefore normal or high in the face
of significant anaemia. Inhibition or blockade of hepcidin
is a potential target for treatment of this form of
Diagnosis and management
It is often difficult to distinguish ACD associated with a
low MCV from iron deficiency.
Examination of the marrow may ultimately be required to assess iron stores
directly.
A trial of oral iron can be given in difficult situations A positive response
occurs in true iron deficiency BUT not in ACD
Measures which reduce the severity of the underlying disorder generally help to improve ACD